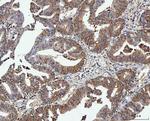
PP2A alpha Antibody in Immunohistochemistry (Paraffin) (IHC (P))

Search
Invitrogen
PP2A alpha Polyclonal Antibody
{{$productOrderCtrl.translations['antibody.pdp.commerceCard.promotion.promotions']}}
{{$productOrderCtrl.translations['antibody.pdp.commerceCard.promotion.viewpromo']}}
{{$productOrderCtrl.translations['antibody.pdp.commerceCard.promotion.promocode']}}: {{promo.promoCode}} {{promo.promoTitle}} {{promo.promoDescription}}. {{$productOrderCtrl.translations['antibody.pdp.commerceCard.promotion.learnmore']}}
图: 1 / 8
PP2A alpha Antibody (PA5-95235) in ICC/IF

Please note: We are reviewing Western blot images included in the antibody testing data in our catalog, including those provided by third parties. Unless expressly labeled or annotated as “raw-unedited”, Western blot images included in the antibody testing data in our catalog may have been edited, optimized or otherwise adjusted for presentation.
产品信息
PA5-95235
种属反应
宿主/亚型
分类
类型
抗原
偶联物
形式
浓度
规格
纯化类型
保存液
内含物
保存条件
运输条件
RRID
产品详细信息
Human PP2A-alpha shares 100% amino acid (aa) sequence identity with both mouse and rat PP2A-alpha.
Reconstitute with 0.2 mL of distilled water to yield a concentration of 500 µg/mL.
Positive Control - WB: human Jurkat whole cell, human MCF-7 whole cell, human 293T whole cell, human Hela whole cell, human HepG2 whole cell, rat brain tissue, rat PC-12 whole cell, mouse lung tissue, mouse liver tissue, mouse brain tissue, mouse NIH/3T3 whole cell. IHC: human colorectal adenocarcinoma tissue, human esophageal squamous carcinoma tissue, human thyroid cancer tissue, mouse brain tissue, rat brain tissue. ICC/IF: U2OS cell. Flow: K562 cell.|Store at -20°C for one year from date of receipt. After reconstitution, at 4°C for one month. It can also be aliquotted and stored frozen at -20°C for six months. Avoid repeated freeze-thaw cycles.
靶标信息
In eukaryotes, the phosphorylation and dephosphorylation of proteins on serine and threonine residues is an essential means of regulating a broad range of cellular functions, including division, homeostasis and apoptosis. A group of proteins that are intimately involved in this process are the protein phosphatases. In general, the protein phosphatase (PP) holoenzyme is a trimeric complex composed of a regulatory subunit, a variable subunit and a catalytic subunit. Four major families of protein phosphatase catalytic subunits have been identified, designated PP1, PP2A, PP2B (calcineurin) and PP2C. The PP2A family comprises subfamily members PP2A alpha and PP2A beta. An additional protein phosphatase catalytic subunit, PPX (also known as PP4) is a putative member of a novel PP family.
仅用于科研。不用于诊断过程。未经明确授权不得转售。
篇参考文献 (0)
生物信息学
蛋白别名: B55-GAMMA; IMYPNO; IMYPNO1; Methyl-PPP2CA; MGC33570; PP2A alpha; PP2A C terminal; PP2A L9; PP2A Leucine 9; PP2A-alpha; PR52; PR55G; protein phosphatase 2 (formerly 2A), catalytic subunit, alpha isoform; protein phosphatase 2, catalytic subunit, alpha isoform; protein phosphatase 2a, catalytic subunit, alpha isoform; protein phosphatase-2A-alpha; Serine/threonine-protein phosphatase 2A catalytic subunit alpha isoform
基因别名: PP2A; Pp2a1; Ppp2ca; R75353
UniProt ID: (Mouse) P63330, (Rat) P63331
Entrez Gene ID: (Mouse) 19052, (Rat) 24672




